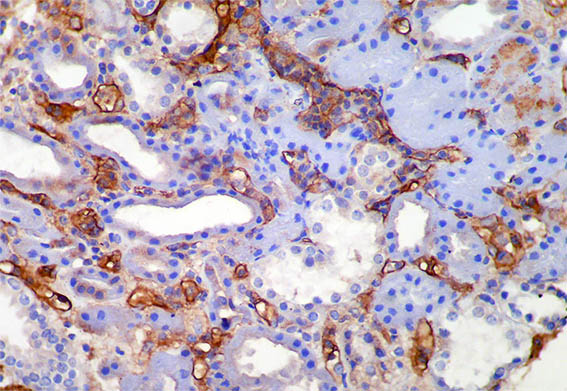

|
|
CASO
212 (octubre de 2023)
Datos clínicos:
Un hombre de 36 años con enfermedad renal crónica terminal de causa desconocida es trasplantado de donante cadavérico. En el pos-trasplante inmediato presenta buena diuresis, con disminución progresiva de la creatinina hasta el 4° día: 1,7 mg/dL, luego queda estacionada y al 7° día sube a 2,9 mg/dL, por lo que se hace biopsia renal. El paciente está asintomático y continúa con buena diuresis. Hemoleucograma normal, plaquetas 234.000/mm2.
Observe las imágenes.

Figura 1. H&E, X100.

Figura 2. H&E, X200.

Figura 3.
H&E, X400.

Figura 4. H&E, X400.

Figura 5. H&E, X400.

Figura 6. H&E, X200.

Figura 7. H&E, X400.

Figura 8. PAS, X400.

Figura 9. Plata-metenamina, X400.

Figura 10. Tricrómico de Masson, X400.
Figura 11. Inmunohistoquímica para C4d: positividad en el 100% de capilares peritubulares, X400.
¿Cuál es su diagnóstico?
Ver
diagnóstico y discusión
[Arriba]
|
|